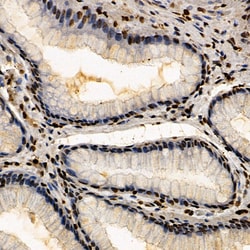

Learn More
Invitrogen™ CSB Polyclonal Antibody


Description
Positive test controls include: 293T, A-549, Mouse thymus, Rat testis. Immunogen sequence: LPVFMEQFSV PITMGGYSNA SPVQVKTAYK CACVLRDTIN PYLLRRMKSD VKMSLSLPDK NEQVLFCRLT DEQHKVYQNF VDSKEVYRIL NGEMQIFSGL I.

Specifications
Specifications
| Antigen | CSB |
| Applications | ELISA, Immunohistochemistry (Paraffin), Western Blot |
| Classification | Polyclonal |
| Concentration | 0.7 mg/mL |
| Conjugate | Unconjugated |
| Formulation | PBS with 50% glycerol and 0.05% ProClin 300; pH 7.3 |
| Gene | ERCC6 |
| Gene Accession No. | Q03468 |
| Gene Alias | 4732403I04; ARMD5; ATP-dependent helicase ERCC6; C130058G22Rik; Chimeric CSB-PGBD3 protein; Chimeric ERCC6-PGBD3 protein; CKN2; Cockayne syndrome group B protein; cockayne syndrome protein CSB; COFS; COFS1; CS group B correcting; CSB; DNA excision repair protein ERCC-6; DNA excision repair protein ERCC-6; ERCC6-PGBD3 fusion protein; ERCC excision repair 6, chromatin remodeling factor; ERCC6; ERCC6-PGBD3 fusion protein (isoform 1); excision repair cross-complementation group 6; excision repair cross-complementing rodent repair deficiency, complementation group 6; POF11; RAD26; UVSS1 |
| Gene Symbols | ERCC6 |
| Show More |
By clicking Submit, you acknowledge that you may be contacted by Fisher Scientific in regards to the feedback you have provided in this form. We will not share your information for any other purposes. All contact information provided shall also be maintained in accordance with our Privacy Policy.